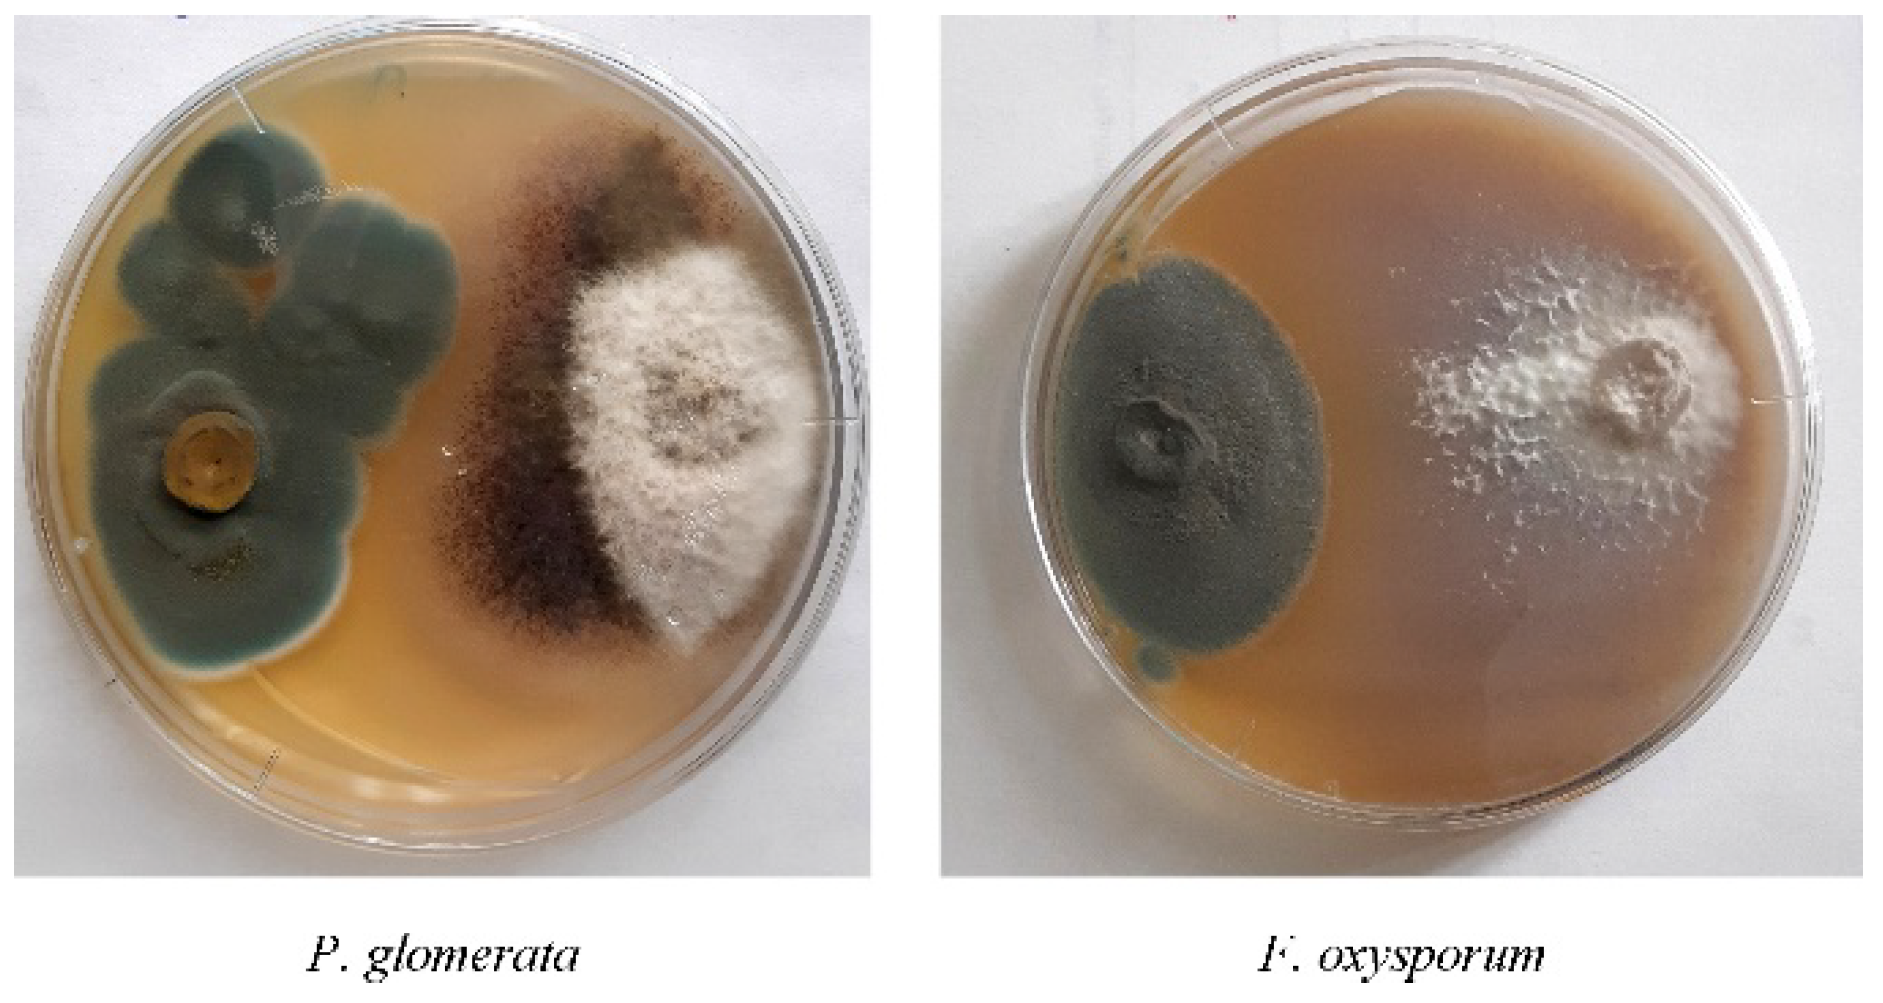
Agriculture 11 00935 g001
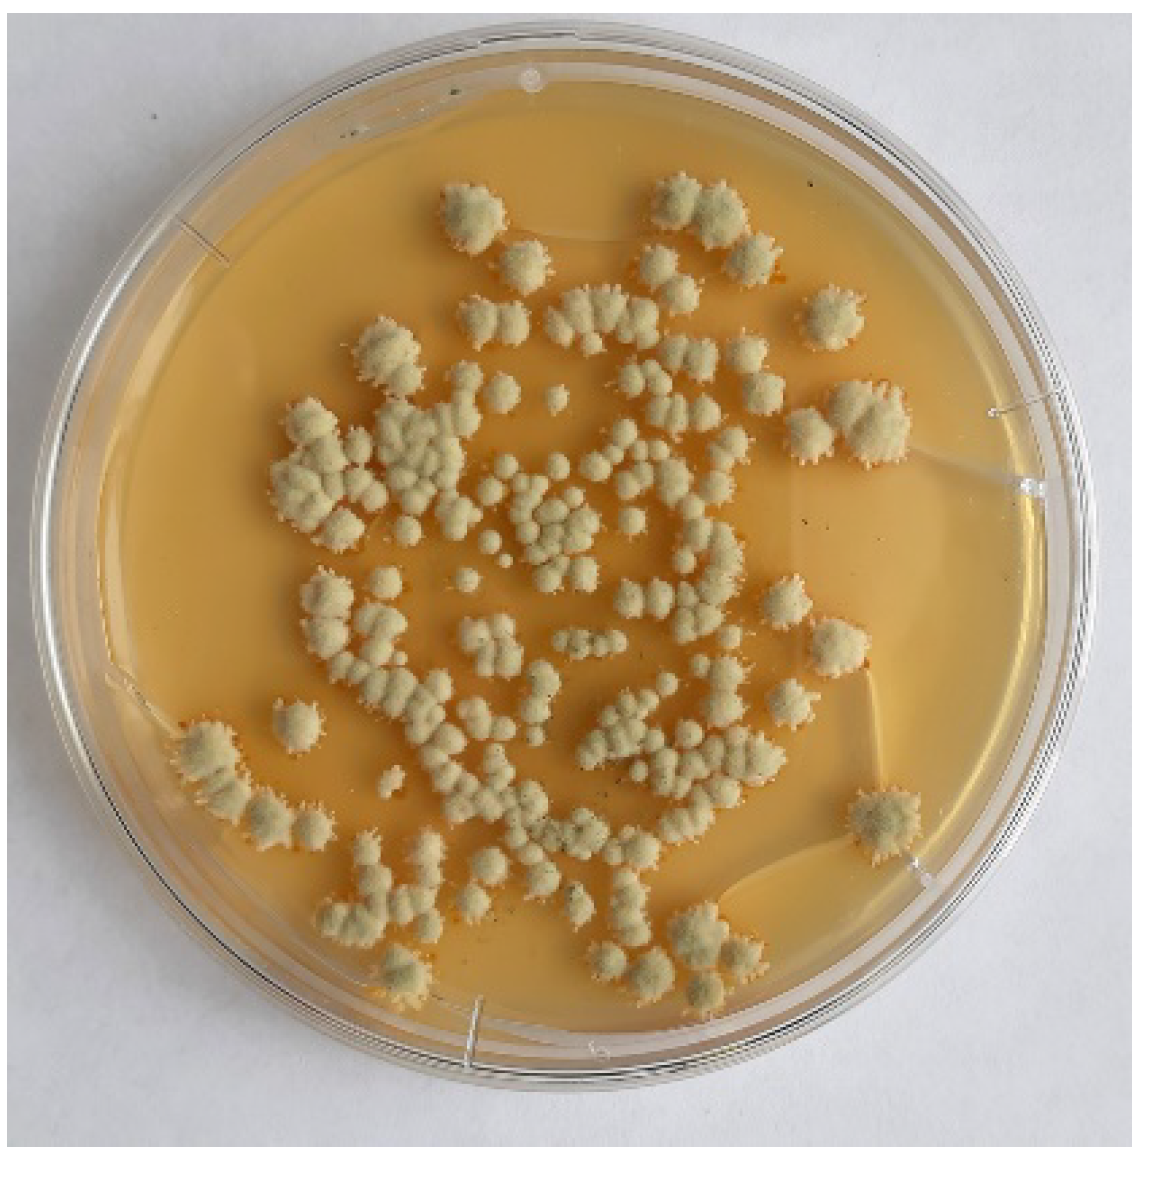
Agriculture 11 00935 g003
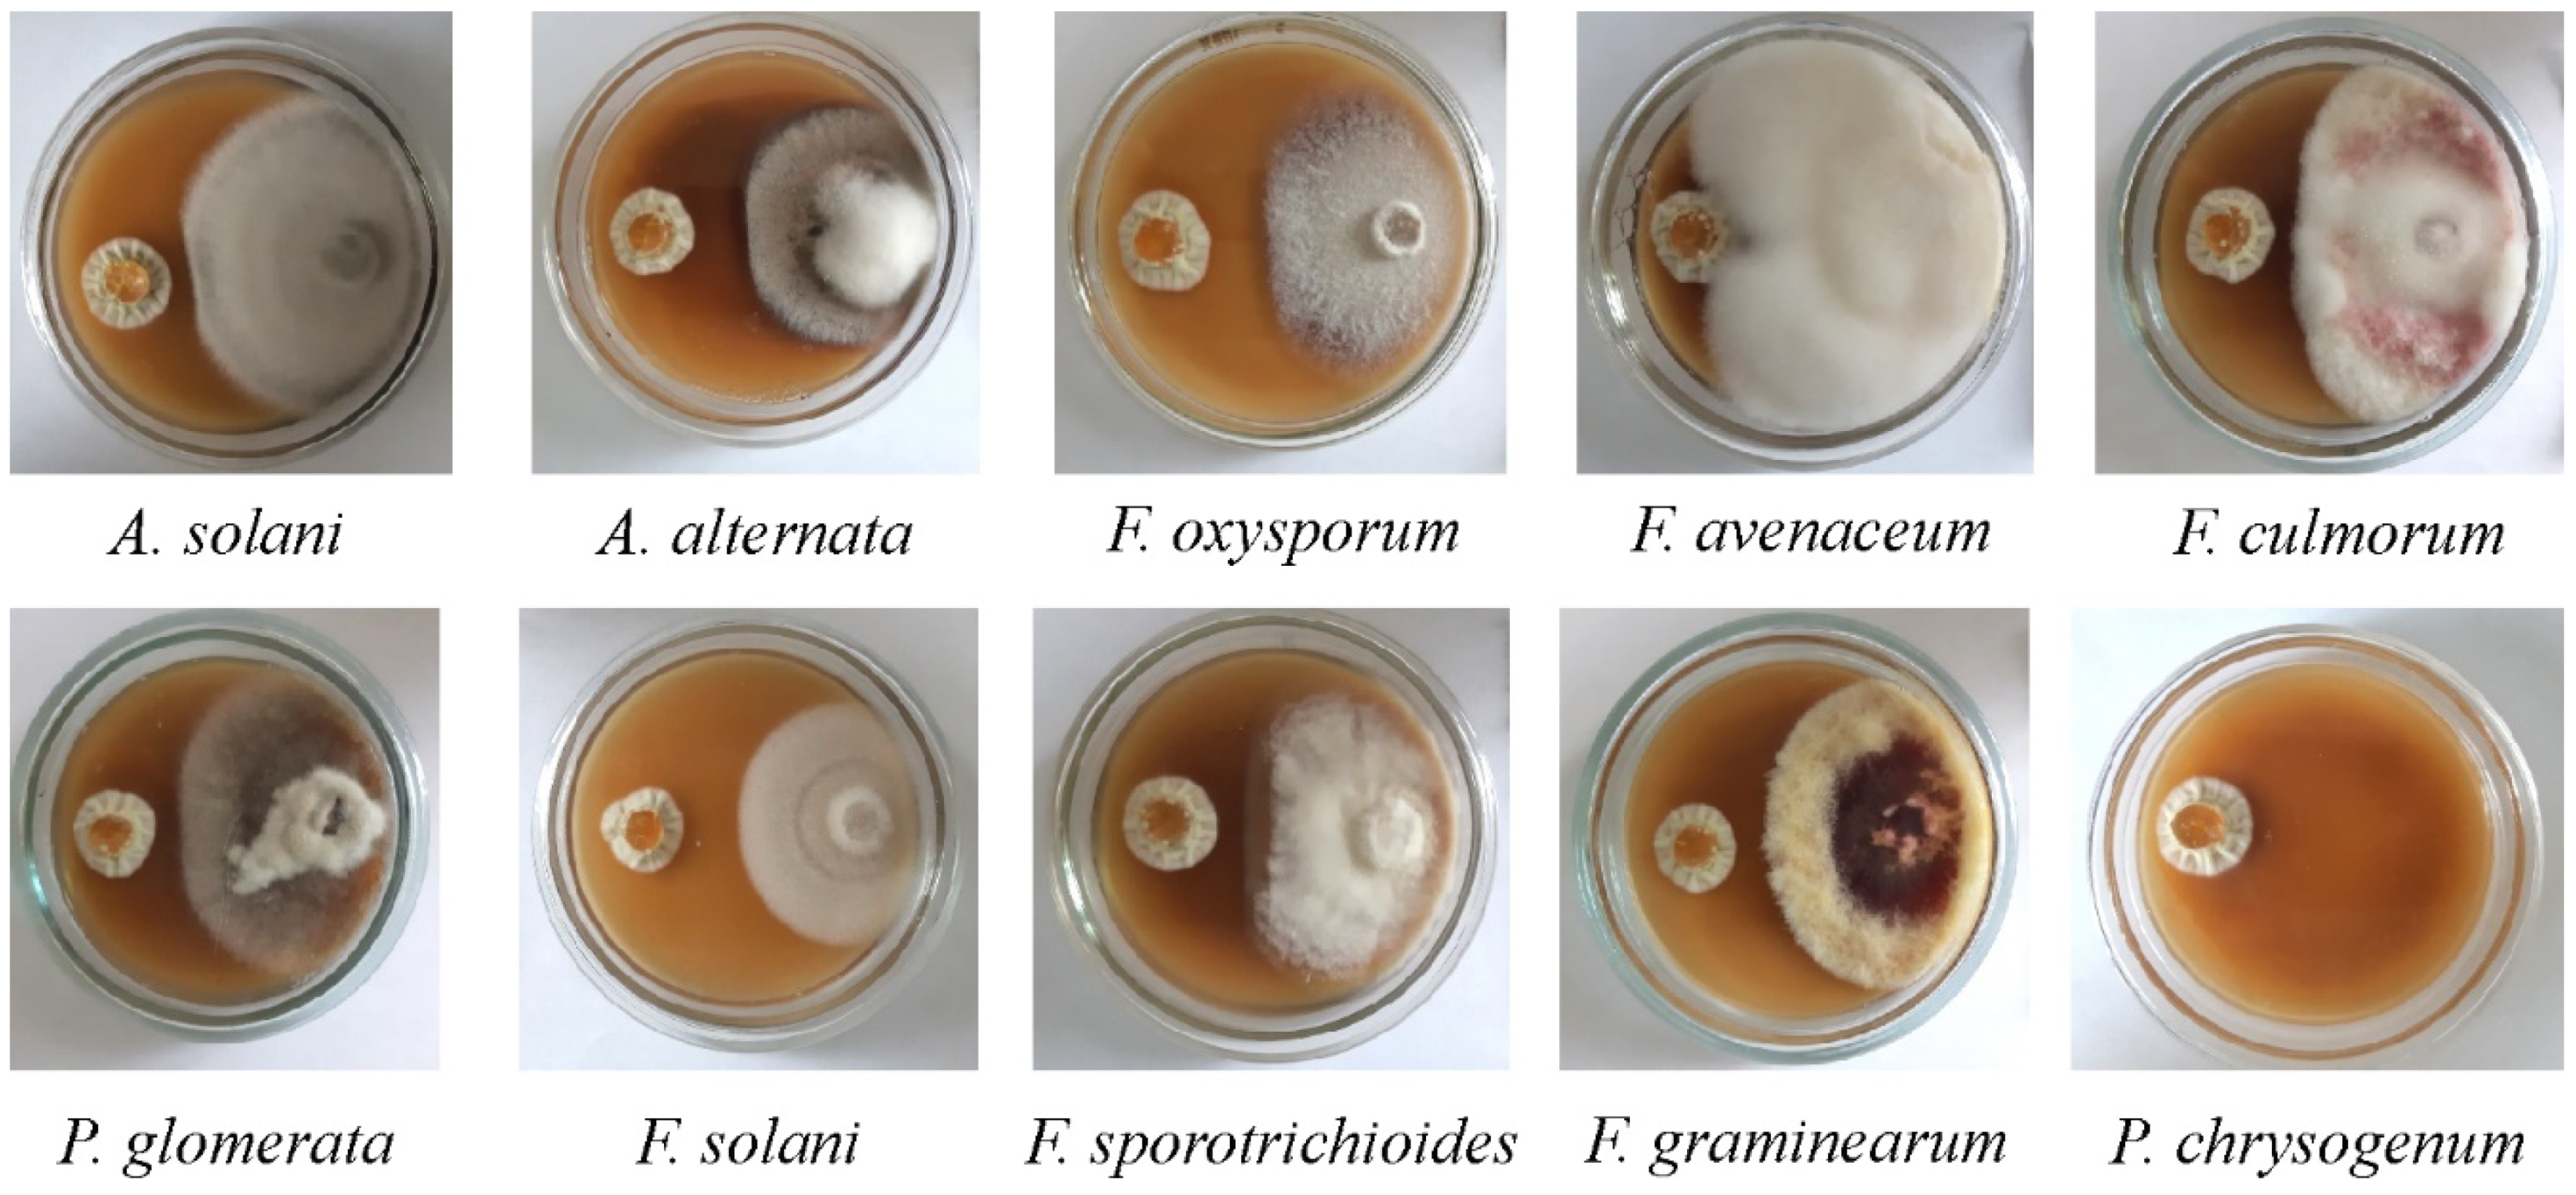
Agriculture 11 00935 g004
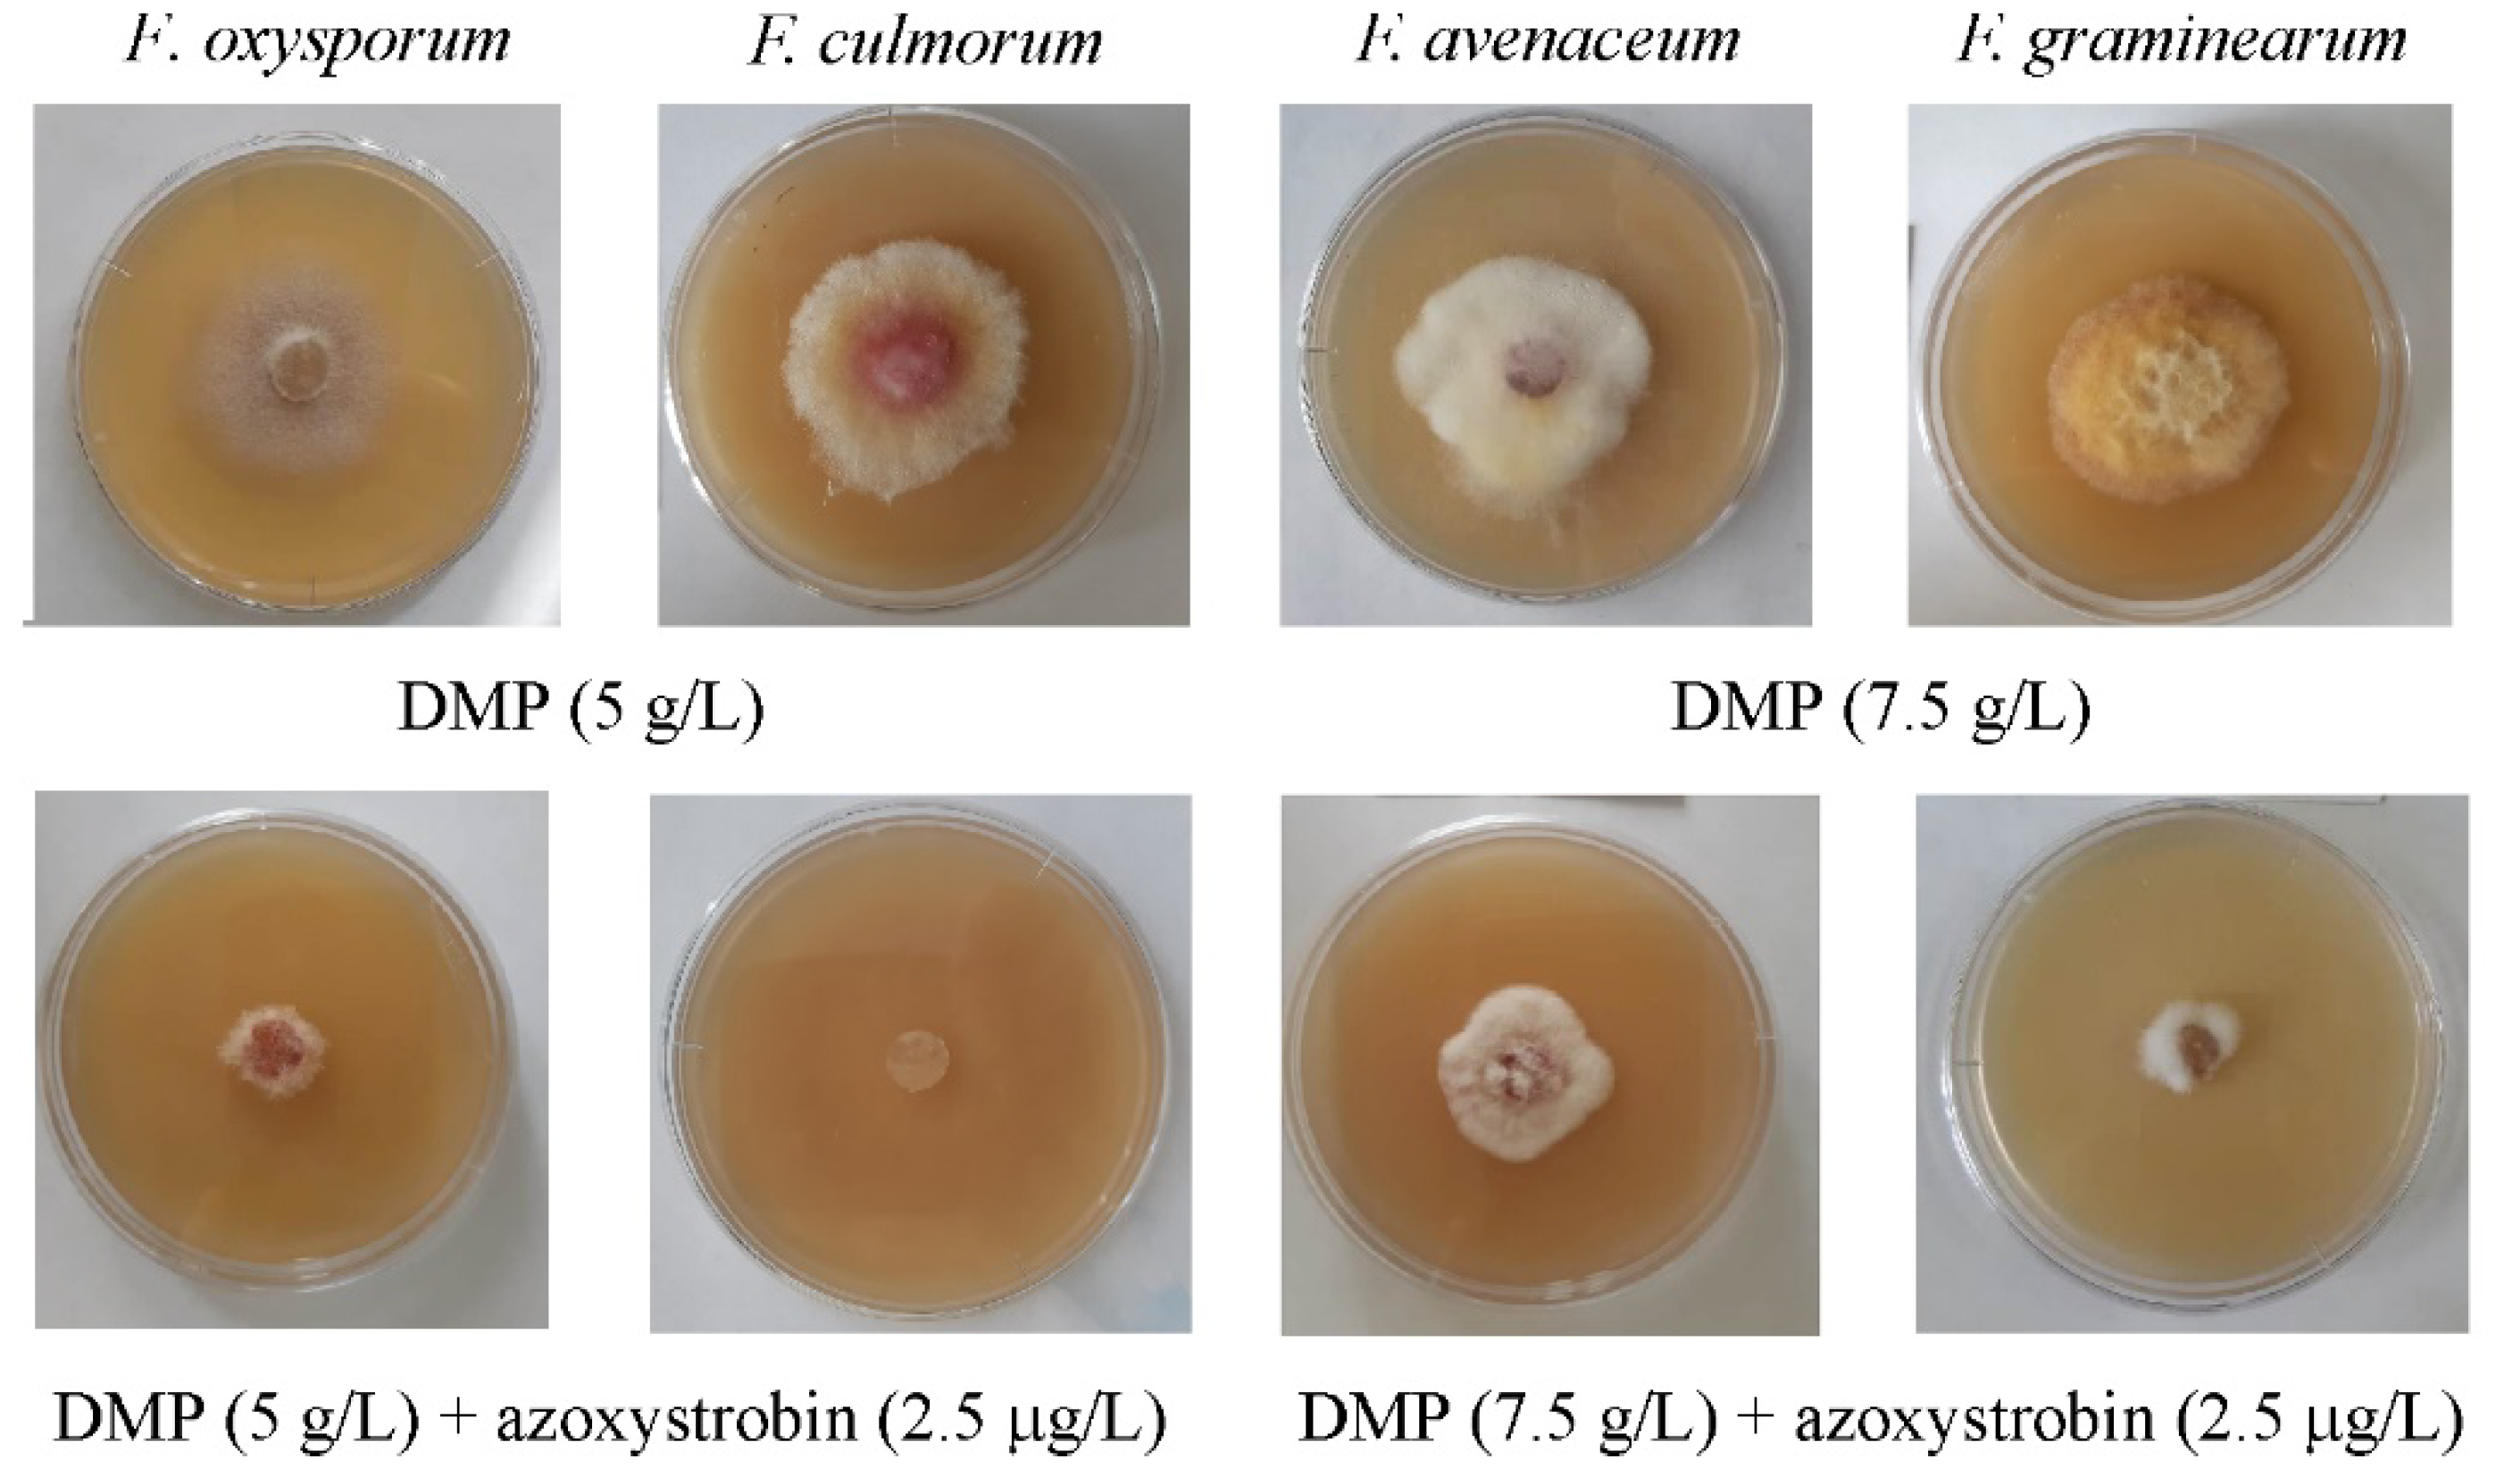
Agriculture 11 00935 g009

1. Introduction
Under the current conditions of the intensive agriculture, crop cultivation strongly requires efficient disease control systems to prevent significant crop losses [
1,
2,
3]. Among the most dangerous plant pathogens, pathogenic fungi take one of the leading positions [
4,
5].
The arsenal of existing approaches to control various plant pathogens, especially those used in intensive plant cultivation technologies, mainly includes chemical methods [
6,
7,
8]. However, in spite of its biological and economical expediency, a wide use of various chemical fungicides resulted in the drop of their efficiency [
9], as well as a significant accumulation of fungicide residues in the soil, water and agricultural production, which poses a serious threat for humans, animals and the whole ecosystem [
10,
11]. Moreover, a progressing resistance of plant pathogens to the chemicals used was revealed [
2,
3,
12,
13].
From the practical point of view, a complete rejection of fungicidal preparations is impossible, since they provide a control of a wide range of diseases [
9]. Taking into account the current trend to the ecologization of agriculture, a search for efficient and ecologically safe approaches to control plant pathogens becomes very relevant. One of the possible solutions is the use of biopreparations based on living microorganisms or their metabolites [
13,
14]. Comparing to chemical fungicides, biological protectants have some valuable advantages, such as safety for humans and animals, high efficiency and selectivity towards a wide range of the known plant pathogens, a lack of resistance to these preparations and high ecological safety [
13].
Biofungicidal preparations consist of natural microbial strains, which possess a significant antifungal activity, and are safe in relation to all ecological niches, including soil, plants, insects, animals and humans. Among potentially useful strains, a special attention should be paid to
Penicillium fungi producing various biologically active compounds [
15] and having a wide range of fungicidal action [
16,
17]. There are also some data on the immuno- and growth-stimulating activity of biopreparations based on the biomass of
Penicillium fungi, which makes it possible to use them in integrated crop protection systems [
18,
19].
Another promising approach to control crop diseases could include a combining of fungicides with biologically active compounds of microbial or plant origin, as well as with their synthesized analogues [
20,
21,
22,
23]. An antifungal effect resulting from the use of such combinations may be either additive, or synergistic; in the last case, synergistic interaction of both components makes it possible to significantly reduce effective concentrations of fungicide preparations until the levels, at which they would be inefficient if applied alone [
4,
10].
In spite of the above-mentioned advantages, however, biological methods of the plant pathogen control are usually inferior to chemical ones in their efficiency. Therefore, the investigation of ways to improve their efficiency, as well as a search and discovery of new biologically active compounds, which can be used to improve the efficiency of modern commercial fungicides, along with the simultaneous reduction of their efficient concentrations, are especially relevant now.
Fusarium fungi belong to major pathogens of agricultural crops. These fungi are very common, and in the majority of cases, represent facultative parasites causing epiphytoties, but only under certain conditions. Plants are affected with a complex of
Fusarium fungi, differing in their biological properties and adapted to certain biocoenotic conditions. The majority of these fungi are able to produce highly toxic metabolites (mycotoxins), such as deoxinivalenol, zearalenone, etc., belonging to different groups of chemical compounds. As a rule, fusariotoxins represent chemically stable compounds that are able to be kept unchanged for a long time in plant-derived food and feed [
24,
25].
The presented study was focused on the investigation of the ability of a dry biomass of
Penicillium chrysogenum F-24-28 to inhibit the growth of plant pathogenic fungi in the case of both individual and combined application with azoxystrobin. Azoxystrobin is a wide-range fungicide, which has been used in agriculture since 1988 [
26]. This agent blocks electron transfer in mitochondria that inhibits adenosine triphosphate (ATP) production, and therefore causes oxidative stress in fungi [
27]. These properties allow one to consider azoxystrobin as an efficient fungicide for plant treatment during vegetation. However, multiple and excessive applications of this compounds may result in the development of resistant pathogen forms, and therefore significantly reduce its efficiency. In addition, there are some data on the toxicity of azoxystrobin for both vertebrates and invertebrates [
9]. Thus, the problem of reduction of working concentrations of both azoxystrobin and fungicides as a whole is very important and relevant.
Taking into account the above-mentioned facts, the purpose of this study was to obtain a highly active fungal strain belonging to the genus Penicillium and the evaluation of its antifungal activity in relation to Fusarium oxysporum, F. avenaceum, F. culmorum and F. graminearum, forming a complex of Fusarium fungi affecting agricultural crops.
2. Materials and Methods
2.1. Microorganisms
At the initial stage of the study, several strains of Penicillium fungi (P. chrysogenum VKPM F-1310 (ATCC 10106), P. chrysogenum VKPM F-321 and P. chrysogenum VKPM F-605) were taken from the work collection of the Laboratory of Biotechnology of Physiologically Active Compounds of the Federal Research Center “Fundamentals of Biotechnology” (Moscow, Russia) to evaluate their possible antifungal activity.
A highly active P. chrysogenum F-24-28 strain was derived from P. chrysogenum VKPM F-1310 by a multi-step selection involving the use of mutagenic factors and directed selection methods.
Strains of Alternaria alternata 100125, A. solani 100053, Phoma glomerata 100085, Fusarium oxysporum MP-14-6, F. graminearum FG-33, F. culmorum BP-03-19, F. avenaceum 110501, F. solani 100021 and F. sporotrichioides 110514 were obtained from the State Collection of Plant Pathogenic Microorganisms of the All-Russian Research Institute of Phytopathology (Bolshie Vyazemy, Russia).
2.2. Reagents and Nutrient Media
Strains of plant pathogens included into the study were grown and maintained on a potato dextrose agar (PDA) medium (Pronadisa Conda, Madrid, Spain).
P. chrysogenum strains used in the study were grown, maintained and selected on nutrient medium consisting of the following components (g/L): agar, 20.0; glucose, 30; glycerin, 70.0; soybean flour, 10; meat peptone, 10; NaNO3, 2.0; MgSO4·7H2O, 1.0 (pH 6.3–6.5).
The used inorganic salts, glycerine and glucose were manufactured by Acros Organics (Geel, Belgium). Agar and meat peptone were manufactured by Difco (Detroit, MI, USA) and HiMedia Laboratories (Mumbai, India), respectively. The skimmed deodorated soybean flour was manufactured by Soyanta 200 (Irkutsk, Russia).
A commercial fungicide Quadris (Syngenta, Basel, Switzerland) containing 250 g/L of azoxystrobin and widely used for crop protection was used as a tested fungicide.
2.3. Development of Highly Active P. chrysogenum F-24-28 Strain
A mutagenic factor used in the study represented ultraviolet (UV) radiation at 250–280 nm. Spore suspension of P. chrysogenum VKPM F-1310 (1.5–2.0 × 106 spores/mL) was poured into an opened sterile Petri plate under sterile conditions and placed under a 12.5-W UV lamp (Mineralight, Jackson, MS, USA) at a distance of 40 cm. The exposure time varied from 0 to 25 min. After the UV treatment, the suspension was inoculated onto potato dextrose agar (PDA) in Petri plates and cultivated at 24 °C for 10–14 days.
A survival rate of colonies was determined as the percentage of colonies grown in the treated variants comparing to the untreated control. At the end of the cultivation, 5–7 morphologically different colonies were selected among other colonies and re-inoculated onto the same medium. Examination of the antagonistic activity of selected colonies was performed by a co-culture assay. A colony possessing the highest antifungal activity was undergone to a UV radiation again with the further examination of the activity of the obtained mutant colonies. In total, seven steps of mutagenesis were performed.
2.4. Evaluation of the Antagonistic Activity by a Co-Culture Assay
The antagonistic activity of the obtained mutant strains was evaluated by a co-culture assay. To obtain agar blocks with the mycelium of P. chrysogenum and plant pathogens included into the study, 0.1 mL of the spore suspension of each fungus adjusted to a concentration of 1 × 106 spores/mL was added to sterile Petri plates with PDA, and spread by sterile spatula. The cultures were incubated at 24 °C for 5 days in the dark. Mycelium-containing 1-cm agar blocks were cut by a sterile drill and transferred to fresh Petri plated with PDA; in each plate, blocks with P. chrysogenum and one of the studied pathogens were placed at a distance of 6 cm between each other. Cultures of antagonists or pathogens cultivated alone were used as a control. The plates were incubated as described above. A visual evaluation was performed at the 7th day of incubation. Each treatment was arranged in three replications and the experiment was repeated three times.
Antagonistic activity (
A) of strains was calculated using the following formula
where
R1 is the colony radius of a pathogenic fungus measured along the axis connecting agar blocks of a pathogen and
P. chrysogenium and
R2 is the colony radius of a pathogenic fungus measured along the same axis in the control variant.
2.5. P. chrysogenum F-24-28 Cultivation in Liquid Medium
To obtain an inoculate, 10 mL of a sterile physiological solution was added into a tube with a fungal culture. The top spore layer was accurately removed by an inoculation loop and transferred into 750-mL flasks containing 100 mL of liquid nutrient medium of the following composition (g/L): sucrose, 100.0; soybean flour, 20; trypton, 10; NaNO3, 2.0; MgSO4·7H2O, 1.0 (pre-sterilization pH 5.7–6.0). The flasks were incubated for 48 h on an Innova 44 incubation shaker (New Brunswick, Edison, NJ, USA) at 24 °C and 220 rpm. After completion of the process, the culture was reinoculated into 1-L flasks containing 250 mL of fermentation medium of the following composition (g/L): sucrose, 100.0; soybean flour, 30; trypton, 10; NaNO3, 2.0; MgSO4·7H2O, 1.0. The volume of the transferred inoculate was 10% of the total incubation volume. Inoculated flasks were placed onto the same shaker and incubated for 96 h under the same conditions.
2.6. Obtaining of a Dry Mycelium Biomass of P. chrysogenum (DMP)
After 96 h of incubation, the biomass of P. chrysogenum was inactivated at 80 °C for 30 min and freeze-dried. The obtained DMP was used for evaluation of its antifungal activity.
2.7. Antifungal Activity Evaluation by a Radial Growth Method
Five grams of DMP was added to 50 mL of sterile physiological solution. The resulted suspension was hydrated by 1-h mixing at 24 °C and 220 rpm on an Innova 44 shaker.
Ready DMP suspension was added to cooled sterilized agar medium using a sterile pipette up to a final concentration of 7.5 g/L. Azoxystrobin solved in sterile water was added to the sterilized agar medium up to a final concentration of 0.1, 0.5, 1.0 and 2.5 mg/L. The resulting media were thoroughly mixed and poured into Petri plates.
Agar blocks with the mycelium of plant pathogens were obtained as described in
Section 2.4. The cut 1-cm blocks were transferred into Petri plates containing agar medium supplemented with DMP, azoxystrobin, or a combination. Plates with pathogen colonies grown on PDA were only used as a control. Inoculated plates were incubated at 24 °C for 14 days in the dark. The diameters of growing colonies were measured at the 3rd, 7th and 14th days of incubation. Each treatment was arranged in three replications, and the experiment was repeated three times.
The antifungal activity (
AFA) of the tested preparations was calculated using the following formula
where
DE and
DC are the colony diameters in the experimental and control variants, respectively (mm).
A possible synergistic effect was determined using a Limpel’s formula [
28]
where
X and
Y represent inhibiting activities provided by each of the tested component (DMP and azoxystrobin) separately (%),
EE is their expected summarized (additive) effect (%) and
ER is the effect obtained experimentally for a joint application of both components (%). If
ER >
EE, then the interaction of the components is considered to be synergistic.
2.8. Mutant Strain Identification
Identification of the obtained strain was carried out at the Laboratory of Molecular Diagnostics of the Center of Bioengineering of the Russian Academy of Sciences. The obtained mutant F-24-28 strain was genetically identified via partial (624 bp) sequencing of a gene encoding a conservative 18S rRNA region using a 18S F566–18S R1200r primer system. A phylogenetic analysis of the obtained nucleotide sequences was performed using a BLAST software and the NCBI GenBank database (
http://www.ncbi.nlm.nih.gov accessed on 13 July 2021), as well as the RDP database classifier (
http://rdp.cme.msu.edu accessed on 13 July 2021). The assembling and editing of the obtained sequences was carried out using a BioEdit software (
http://jwbrown.mbio.ncsu.edu/BioEdit/bioedit.html accessed on 13 July 2021). To exclude chimeras, the obtained sequences were checked using an online CHECK_CHIMERA tool of the Ribosomal Database Project resource (
http://rdp.cme.msu.edu accessed on 13 July 2021).
2.9. Data Treatment
The experiment on the evaluation of the growth of pathogenic fungi in the presence of DMP, fungicide, or a combination was repeated three times, each in three replications. The obtained arithmetical means of colony diameters were used for the further calculations. The statistical treatment of data was carried out using a “STATISTICA 6.0” program package (StatSoft, Inc., Tusla, OK, USA). The diagrams show arithmetical means and standard errors. The significance of differences between the control and experimental values (p < 0.05) was determined using a Student’s t-test for independent variables.
3. Results
3.1. Evaluation of the Antagonistic Activity of Penicillium Fungi and Selection of a Parental Strain
At the initial stage of the study, three strains of
Penicillium fungi were evaluated for their antagonistic activity towards several pathogens characterized by a wide range of their possible hosts (
F. oxysporum MP-14-6,
A. solani 100053 and
P. glomerata 100085). The evaluation was carried out by a co-cultivation assay, as described in
Section 2.4.
Among three studied strains, the highest antagonistic activity in relation to the used plant pathogens was revealed in
P. chrysogenum VKPM F-1310. In the case of its co-cultivation with
P. glomerata 100085 or
F. oxysporum MP-14-6, a 5–6-mm inhibition zone was observed (
Figure 1). The antagonistic activity of the strain calculated according to the formula presented in the
Section 2.4 was 60 and 55%, respectively.
In the case of co-cultivation with A. solani 100053, an intensive growth of the antagonist with a gradual spreading of P. chrysogenum VKPM F-1310 onto a pathogen colony was observed. Other two Penicillium strains demonstrated a weak antagonistic activity towards the studied pathogenic strains, which did not exceed 15–20% on average.
Thus, P. chrysogenum VKPM F-1310 strain was chosen for the further development of a highly active antagonistic strain.
3.2. Mutagenesis and Development of Highly Active P. chrysogenum F-24-28 Strain
The chosen F-1310 strain was undergone to the UV mutagenesis combined with the selection of isolated mutant colonies phenotypically differing from the initial strain and possessing the highest antagonistic activity towards three universal plant pathogenic fungi.
The optimum exposure time was determined by the survival rate of colonies and the frequency of appearance of colonies with changed morphophysiological features. The results of the experiment are shown in
Figure 2. According to the constructed curves, the optimum exposure time provided the maximum frequency of morphological changes (28%) and a significant survival rate (2–2.5%) was 20 min.
After the UV exposure and PDA inoculation with the treated suspension, 7–10 colonies differing from the control ones in their form and/or color were selected for the further examination. Though this approach is rather subjective in some aspects, it is actually based on frequent cases of correlation between the morphological and metabolic changes [
29]. It is known that highly productive strains are often characterized by poor or excess sporulation, may lose their pigmentation or acquire it, or may change the size or form of their colonies, etc. The selected colonies were tested for their antagonistic activity towards three plant pathogenic strains listed in
Section 3.1, and the best one underwent a new stage of the mutagenesis and selection. After a series of consecutive mutagenesis stages, a new strain characterized by felt-like greyish-green colonies with uneven edges was obtained (
Figure 3). This strain (
P. chrysogenum F-24-28) possessed a high antifungal activity confirmed by a co-culture assay in relation to
A. solani,
A. alternata,
F. oxysporum,
F. sporotrichioides,
F. graminearum,
F. avenaceum,
F. culmorum,
F. solani and
P. glomerata (
Figure 4 and
Figure 5).
3.3. Strain Identification
The performed BLAST analysis allowed us to determine the nucleotide sequence of the fragment of a 18S RNA gene from
Penicillium chrysogenum F-24-28 (
Figure S1).
Using the ITS1–ITS4 primers, we also determined a 567-bp sequence encoding the intergenic region of the ribosomal operon (
Figure S2).
The resulted sequence from the 18S RNA gene of the
P. chrysogenum sample was 100% identical to those of
P. chrysogenum CBS 306.48,
P. leycettanus CBS 398.68 and
P. commune CBS 343.51 (the search algorithm included typical sequences from the NCBI database (
https://www.ncbi.nlm.nih.gov/ accessed on 13 July 2021).
The ITS region of the studied
P. chrysogenum sample was 100% identical to those of
P. tardochrysogenum CBS 132200 and
P. chrysogenum CBS 306.48 (the search algorithm included typical sequences from the NCBI database (
https://www.ncbi.nlm.nih.gov/ accessed on 13 July 2021).
3.4. Effect of DMP on the Growth F. oxysporum, F. graminearum, F. avenaceum and F. culmorum
The antifungal activity of DMP was evaluated using four plant pathogenic fungi (
F. oxysporum MP-14-6,
F. graminearum FG-33,
F. culmorum BP-03-19 and
F. avenaceum 110501) causing the development of
Fusarium rots and wilts in agricultural crops. At this stage, a comparative study of the effect of different amounts of DMP added to a nutrient medium on the growth of plant pathogens was carried out by the radial growth method. The results of the study are shown in
Figure 6.
The obtained results made it possible to conclude that DMP possessed a different inhibiting activity towards the studied plant pathogens. F. oxysporum MP-14-6 and F. culmorum BP-03-19 strains were the most sensitive: at DMP concentrations equal to 7.5–10 g/L, almost complete inhibition of their growth was observed at the 3rd and 7th days of incubation, and a small colony growth was observed at the end of the experiment (14th day of incubation). Comparing to both above-mentioned Fusarium strains, F. graminearum FG-33 was less sensitive within the studied DMP concentration range. A high antifungal effect (80 and 88%) was observed at the 3rd day of the experiment for high biomass concentrations (7.5 and 10 g/L, respectively). At the 7th day of incubation, a high antifungal effect (64 and 70%) was registered only for MP concentrations equal to 7.5 and 10 g/L, respectively. At the 14th day of incubation, an active pathogen spreading over the Petri plates was observed even for the maximum DMP concentration (10 g/L); the resulting antifungal effect was 38%.
F. avenaceum 110501 was the less sensitive to the studied DMP concentration range. At the 7th day of incubation, a significant colony growth was observed for lower DMP concentrations (2.5–7.5 g/L); for the concentration variant of 7.5 g/L, an inhibiting activity of DMP did not exceed 42%. An increase of the DMP concentration to 10 g/L resulted in an increase of its antifungal activity of up to 54%. To the end of incubation (14th day), F. avenacium mycelium spread over the whole Petri plate surface at low DMP concentrations (2.5–5 g/L); in the case of the maximum DMP concentration (10 g/L), the revealed antifungal activity did not exceed 21%.
Thus, within the studied concentration range, the antifungal activity of DMP towards Fusarium fungi is decreased in the following way: F. oxysporum > F. culmorum > F. graminearum > F. avenaceum.
At the next stage of the study, the antifungal activity of DMP–azoxystrobin combinations was evaluated within the azoxystrobin concentration range of 0.1–2.5 mg/L. Note that the DMP concentration added to the nutrient medium varied depending on a pathogen strain: 5.0 g/L for the most sensitive fungi (F. oxysporum and F. culmorum) and 7.5 g/L for other two fungi (F. graminearum and F. avenaceum).
3.5. Evaluation of Antifungal Activity of DMP–Azoxystrobin Combination towards F. oxysporum, F. culmorum, F. graminearum and F. avenaceum
In the case of
F. oxysporum MP-14-6 (
Figure 7A–C), the antifungal activity of azoxystrobin within the chosen concentration range (0.1–2.5 mg/L) was insignificant; at the 14th day of incubation, the plate was completely covered by the fungal mycelium. However, combination of the DMP and the fungicide provided a high (>50%) colony growth suppression for the whole observation period at the fungicide concentration range of 0.5–2.5 mg/L. Note that the variants included DMP only (5 g/L) and DMP (5 g/L)—azoxystrobin (0.1–2.5 mg/L) combinations showed rather insignificant colony growth at the 7th and 14th days of experiment.
A high antifungal effect (>50%) of the DMP (5 g/L) combination with azoxystrobin (0.1–2.5 mg/L) was also observed in the experiments with
F. culmorum (
Figure 7D–F). At the 3rd day of incubation, the inhibiting activity of the fungicide within the studied concentration range was 53.7–65% and the mycelium completely spread over the agar surface to the 14th day of incubation. At the same time, combination of DMP even with the minimum concentration of the fungicide (0.1 mg/L) resulted in a significant inhibition of the
F. culmorum growth (see
Figure 7D); the registered antifungal activity was 88%. A high antifungal efficiency of the DMP (5 g/L) and azoxystrobin (0.1–2.5 mg/L) combinations was maintained for the whole period of observations.
Compared to both
F. oxysporum and
F. culmorum strains, the
F. graminearum FG-33 strain was less sensitive to DMP (
Figure 8A–C). At the 3rd day of incubation, an antifungal activity of azoxystrobin within the chosen concentration range varied between 53.4–60.3%; a full spreading of the mycelium over the agar surface was observed at the 7th day for azoxystrobin concentrations equal to 0.1 and 0.5 mg/L and at the 14th day for the two lower concentrations (1 and 2.5 mg/L). In the case of all DMP (7.5 g/L) and fungicide combinations, a significant (>50%) colony growth inhibition was observed at the 3–7th days of incubation. The effect still remained at the 14th day of incubation for all combination variants, excluding that with the azoxystrobin combination equal to 0.1 mg/L.
Among plant pathogenic
Fusarium fungi included in the study,
F. avenaceum 110501 was the most resistant to the inhibiting action of both azoxystrobin and DMP (
Figure 8D–F). Though a high growth-inhibiting activity of the DMP combinations with azoxystrobin (0.1–2.5 mg/L) towards other
Fusarium fungi was observed even at the 14th day of incubation, but in the case of
F. avenaceum, the value of the same parameter determined at the 14th day of incubation decreased to the minimum value (13%) in the variant with the minimum azoxystrobin concentration (0.1 mg/L).
The typical appearance of Petri plates with the studied pathogens and combinations of preparations are shown in
Figure 9.
Analyzing data presented on
Figure 5,
Figure 6 and
Figure 7, one should note the following trend observed for
F. oxysporum,
F. culmorum,
F. graminearum and
F. avenaceum. If the experimental antifungal effect (
ER) of all DMP–azoxystrobin combinations observed at the 3rd day of incubation was equal or insignificantly exceeded the calculated additive effect of these two compounds (
EE), then the difference between
ER and
EE at the 7th and 14th days of incubation may reach 20–50% depending on a pathogen.
Thus, the obtained results can be considered as evidence of the high efficiency of the studied DMP–azoxystrobin combinations in relation to such plan pathogenic fungi as F. oxysporum, F. culmorum, F. graminearum and F. avenaceum.
4. Discussion
Disturbance of the biological equilibrium in the nature, the accumulation of pesticide residues in agricultural products and the progressive pesticide resistance of plant pathogens are the key factors limiting the use of chemical plant protectants in the modern agriculture. Nevertheless, the use of various fungicides differing in their chemical structure and mechanism of action still remains an efficient tool to control plant pathogens, especially under conditions of intensive agriculture. Therefore, the development of environmentally safe preparations able to enhance the action of commercial fungicides even at the minimum possible concentrations—as well as to reduce their selective pressure on pathogen populations accelerating the appearance and selection of resistant genotypes—is a very urgent and important task. One of the possible ways of its accomplishment is the use of biomethods based on the use of microorganisms or their metabolites possessing biocide activity or nontoxic organic or inorganic compounds, enhancing the sensitivity of target microorganisms to chemical fungicides [
4,
21].
Among promising strains suitable for the development of antifungal biopreparations,
Penicillium fungi, which synthesizes various biologically active compounds of both a protein and non-protein nature and possesses a wide range of antimicrobioal and antiviral activity, are of special interest [
15,
30,
31]. Preparations obtained based on the
Penicillium biomass may be used as efficient biopreparations for the plant protection [
30,
32].
Fusarium fungi attract attention of numerous researchers [
25,
33]. Representatives of this genus included in this study (
F. oxysporum,
F. graminearum,
F. culmorum and
F. avenaceum) are very common pathogens infecting wheat, rye, barley, oats and many other crops [
15]. Since these fungi are cosmopolitian species characterized by a high adaptability and (sometimes) aggressiveness, wide host range and rapid evolution, their appropriate control is a very difficult task. From this point of view, the development of approaches providing an efficient inhibition of these fungi using minimum fungicide concentrations is a very interesting practical question.
This study was directed to develop a strain possessing a high antifungal activity, and is able to enhance the efficiency and duration of action of a commercial fungicide azoxystrobin in the case of a joint application. Enhancement of the pathogen sensitivity to fungicides by various nontoxic substances, or chemosensitization, is now one of the promising directions of studies in the field of crop protection. The effect of a combined application of a fungicide and a sensitizer can be either additive, or synergistic [
10,
33]. The obtained mutant
P. chrysogenum F-24-28 strain demonstrated a high antagonistic activity to some plant pathogenic fungi. It was shown that the dry biomass (DMP) of the obtained strain provided growth-inhibiting effect towards four
Fusarium species, and these fungi had a different sensitivity to DMP.
The presence of such inhibiting effect of DMP can be explained by the fact that, according to the existing data, it may contain various metabolites possessing antifungal action [
30,
31]. For example, small cationic cystein-rich proteins PAF and PAFB from
P. chrysogenum characterized by a high pH stability and resistance to heat and proteolysis demonstrated a high growth-inhibiting activity towards a wide range of pathogenic fungi even in micromolar concentrations, as well as possessing both in vitro and in vivo antiviral action without any cytotoxic effect on mammal cells [
16,
34]. The mechanism of action of these proteins is based on a hyperpolarization of a plasmatic membrane resulting in the disturbance of a cell homeostasis, including osmotic equilibrium. As a result, the activation of ionic channels occurs with the further increase in the content of reactive oxygen species in a cell, and the induction of its apoptosis [
16]. A high stability of PAF and PAFB within a wide range of pH and temperature made them suitable for therapeutic use in medicine, as well as crop and food protection. Another compound, 6-demethylmevinolin (6-DMM) produced by
P. citrinum was found to influence on both colony growth and conidial germination of
A. solani,
A. alternata,
P. nodorum and
R. solani, as well as four
Fusarium fungi (
F. avenaceum,
F. culmorum,
F. oxysporum and
F. graminearum) forming together with
Bipolaris sorokiniana a complex of root rots of wheat [
33]. Like triazoles, 6-DMM inhibits the biosynthesis of sterols forming fungal cell walls; however, unlike DMI fungicides, its target is 3-hydroxy-3-methylglutaryl CoA-reductase, which is involved in the early stages of the sterol biosynthesis. Authors of this study demonstrated a high synergistic effect of a combined application of 6-DMM and a Folicur KE 25% fungicide.
The performed evaluation of the DMP activity towards the target pathogens allowed us to determine sublethal concentrations of a preparation suitable for the evaluation of a possible synergistic interaction with azoxystrobin. In the case of F. oxysporum and F. culmorum strains, it was equal to 5 g/L, which provided the colony growth inhibition of these strains at the 7th/14th days of incubation at the levels of 63/45 and 71.4/49.6%, respectively. For F. graminearum and F. avenaceum strains, which manifested a higher resistance to DMP, the sublethal concentration was determined at the level of 7.5 g/L; the corresponding colony growth inhibition at the 7th/14th days of incubation was 64/28 and 42/15%, respectively.
The studied fungal strains also had a different level of sensitivity to azoxystrobin. Use of this fungicide at concentrations of 5–10 mg/L completely inhibited the growth of fungal colonies (data not shown). In this case, evaluation of either an additive or synergistic effect would be impossible. Thus, for evaluation of a possible synergism we used a lower concentration range (0.1–2.5 mg/L), for which the resulted growth-inhibiting activity at the 3rd–7th days of incubation slightly exceeded 50%.
Excepting F. avenaceum, cultivation of three other pathogens (F. oxysporum, F. graminearum and F. culmorum) on media containing both DMP and azoxystrobin resulted in a high colony growth inhibition during the whole period of incubation for the fungicide concentrations within the range of 0.5–2.5 mg/L.
The obtained results demonstrated that DMP itself has a high antifungal activity exceeding that of azoxystrobin taken in the chosen range of concentrations (0.1–2.5 mg/L). A combination of DMP with azoxystrobin resulted in the maximum stable colony growth inhibition; the only exception was the case of F. avenaceum, for which the growth-inhibiting activity of the tested DMP-azoxystrobin combinations measured at the 14th day of incubation did not exceed 30%.
For all tested combinations, the additive growth-inhibiting effect (EE) calculated by the Limpel’s formula for the 3rd day of incubation was almost the same or slightly lower than the experimentally obtained ER values. At the same time, at the later stages (7th and 14th days of incubation), the difference between EE and ER values increased. This fact may be considered as an evidence of a high efficiency of the joint application of DMP and azoxystrobin.
The higher antifungal effect observed for a combined use of both compounds may be connected with the action of various components of the fungal biomass. Compounds enhancing the sensitivity of plant pathogens to fungicides attack methabolic pathways controlling the defense response of a microorganism to the oxidative stress, and also increase this stress provoking generation of toxic reactive oxygen species and disrupt cell and vacuolar membranes, which results in osmotic stress and apoptosis [
4]. Therefore, DMP-caused homeostatic imbalance in microbial cells, together with the action of chemical fungicides may result in the maximal death of plant pathogens, even at minimal concentrations of active substances.
The results of this study may represent very useful practical factor directed onto the control of the growth and development of a pathogen population below the level of their economical harmfulness. The further work will include the isolation and identification of DMP compounds, providing its antifungal activity.